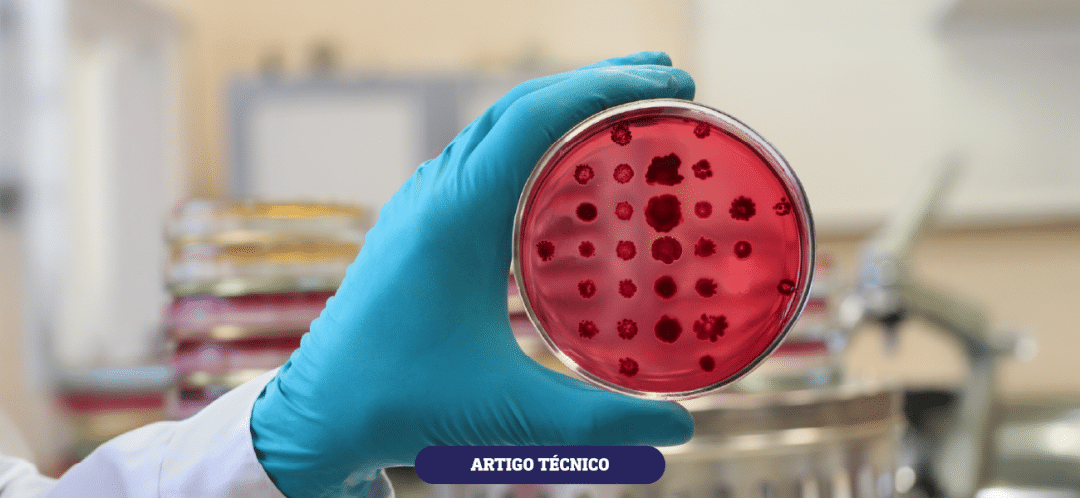

por Susana Cazerta, Gerente de Serviços ao Cliente da ADM
Existem, aproximadamente, 250 tipos de doenças transmitidas por alimentos (DTA), sendo a maioria delas causada por bactérias e suas toxinas. A Salmonella está entre os principais patógenos causadores de DTA e a terceira principal causa de mortes (WHO, 2023). A ingestão de produtos de origem animal contaminados, tais como ovos, carnes de aves e suínos, entre outras carnes é a principal via de transmissão em humanos (Marder et al., 2017). As infecções por Salmonella representam uma grande preocupação para a saúde pública, animais e indústria de alimentos em todo o mundo. Além disso, ainda causa perdas econômicas devido às restrições a barreiras comerciais.
A Salmonella é uma bactéria gram-negativa pertencente à família Enterobacteriaceae, bastonete flagelados, anaeróbia facultativa com pH ótimo em torno de 7, temperatura ideal entre 35 e 37°C e tolerância de salinidade superior a 9%. A Salmonella é classificada em sorovares, sendo que existem mais de 2.500 conhecidos com cepas que diferem em virulência (Morasi et al., 2022).
Existem muitos vetores de transmissão de Salmonella para aves e produtos de origem animal, como matrizeiros, incubatórios, granjas, roedores, pássaros silvestres, fábricas de ração, plantas de processamento e o homem. Desse modo, para o controle eficaz deste patógeno é fundamental que se faça uma abordagem sistêmica, sendo necessário conhecer as rotas de transmissão, fontes de contaminação, sua prevalência dentro do sistema de produção animal e a adoção de medidas de controle e intervenções ao longo da cadeia.

Neste contexto, as rações contaminadas representam um risco de contaminação dos lotes de aves e subsequentemente de produtos de origem animal para consumo humano. Os princípios de controle de Salmonella na fábrica de rações podem ser divididos em três categorias: (1) esforços para prevenir a entrada da contaminação; (2) esforços para reduzir a multiplicação da contaminação dentro de planta e (3) procedimentos para eliminação do patógeno. A prevenção da entrada da contaminação envolve a qualificação dos fornecedores de matérias-primas, o controle do fluxo de pessoas e processo, controle da infestação por pragas e a limpeza e sanitização dos veículos de transporte. A redução da multiplicação da Salmonella envolve a adoção de procedimentos eficazes de limpeza, a redução do pó no ambiente fabril, bem como a implementação e manutenção das boas práticas de fabricação. Procedimentos para eliminação do patógeno envolvem o processamento térmico das rações e o emprego de antisalmonella nas rações e matérias-primas. O processamento térmico reduz, mas devido a recontaminação da ração após esse processo, a associação dos dois métodos de controle se mostra eficaz para o controle deste patógeno.
Diante do exposto e de encontro às necessidades do mercado, a ADM possui uma linha completa de antisalmonella a base de formaldeído: Salmex e Betabacter, e ácidos orgânicos (fórmico, ácido lático e propiônico): Premium Eco, Betacleaner e BetaSal, com fórmulas exclusivas e com comprovado efeito no controle de Salmonella nas rações, matérias-primas e ingredientes. Além dos produtos, o programa antisalmonella conta com a instalação de equipamentos de dosagem por uma equipe técnica especializada, além de um robusto pacote de serviços técnicos personalizados de encontro às necessidades do cliente.
NUTRINDO HOJE O NOSSO AMANHÃ.